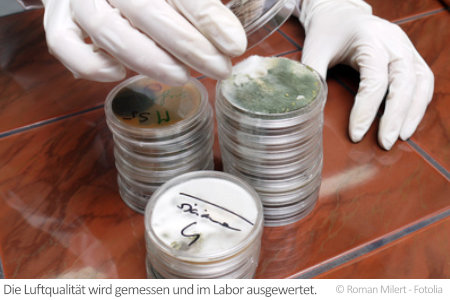
Luftqualität gemessen

Luftqualität messen
Daten und Fakten: Luftqualität messen
Die Außenluft ist in Industrieländern mit einer Vielzahl von Schadstoffen belastet. Obwohl in Deutschland die Schadstoffbelastung mit Industrieschadstoffen in den letzten Jahrzehnten deutlich abgenommen hat, ist gerade in Großstädten die Außenluft weiterhin stark mit Feinstaub belastet. Dieser dringt natürlich auch in Wohnräume ein.
Wird die Luftqualität in Innenräumen gemessen, zeigen sich zusätzlich sehr oft Belastungen mit Wohngiften, die aus Einrichtungsgegenständen oder Baumaterial entweichen. Für die Messung der Luftqualität stehen verschiedene Verfahren zur Verfügung.
Welche Wohngifte können die Luft in Innenräumen belasten?
Luft in Wohnräumen und im Freien sollte grundsätzlich frei von gesundheitsschädlichen Substanzen und störenden Gerüchen sein. In Urin und Blut von Erwachsenen aus Industrieländern wurden jedoch teilweise über 200 Chemikalien nachgewiesen. Ein Teil dieser Chemikalien wird in der heimischen Wohnung über die Luft aufgenommen.
Beim Messen der Luftqualität werden besonders häufig Lösungsmittel aus Klebstoffen, Farben und Lacken festgestellt. Auch Formaldehyd aus Spanplatten und Weichmacher aus Kunststoff zählen zu den oft gemessenen Schadstoffen.
Die Luftqualität
wird aber auch durch gefährliche polyzyklische aromatische
Kohlenwasserstoffe (PAKs) und Holzschutzmittel wie Lindan und PCP
belastet. Im Hausstaub sammeln sich außerdem teilweise
gesundheitsschädliche Fasern aus Dämmmaterialien (z.B. Mineralwolle)
oder Asbest.
Wird die Luftqualität in Wohnungen von Rauchern gemessen, zeigen sich bei professionellen Analysen oft hunderte Schadstoffe. Zu den gefährlichsten Vertretern zählen dabei Benzol und Teerverbindungen. Zu den Luftschadstoffen werden vielfach auch die Sporen von Schimmelpilzen gezählt.
Mit welchen Verfahren wird die Luftqualität gemessen?
Bei den Verfahren zum Messen der Luftqualität wird grob in Aktivsammler, Passivsammler und die Kultivierung von Mikroorganismen unterschieden.
Aktivsammler pumpen zum Messen der Luftqualität eine genau definierte Menge Luft durch ein Proberöhrchen. Auf einem spezifischen Trägermedium sammeln sich die Schadstoffe. Vorteil der Methode ist, dass das Messen der Luftqualität durch das große gepumpte Luftvolumen oft schon nach wenigen Minuten abgeschlossen ist.
Im
Gegensatz zum Aktivsammler erfolgt beim Passivsammler die Probeentnahme
nur durch die natürliche Diffusion (kein mechanisches Pumpen) der Luft
durch das Proberöhrchen. Als Trägermedium wird hier oft Aktivkohle
verwendet.
Das Messen der Luftqualität mit einem Passivsammler kann mehrere Wochen dauern.
Das eigentliche Messen der Luftqualität
erfolgt bei Aktiv- und Passivsammlern durch Auswertung der Trägermedien
im Labor. Schimmelsporen werden mit einem Test auf koloniebildende
Einheiten (KBE) erfasst. Dazu werden Petrischalen mit einem Nährboden in
verschiedenen Räumen für einige Stunden aufgestellt
(Sedimentationsmethode). Die Petrischalen werden dann im Labor für
einige Tage bebrütet („inkubiert“).
Durch die Größe der gewachsenen Schimmelpilzkulturen können dann Rückschlüsse auf die Belastung der Luft geschlossen werden.

Prüfen Sie mit der Luftanalyse Wohnraum Standard flüchtige organische Verbindungen.
✔️ 48 leichtflüchtige Parameter (VOC)
✔️ inkl. TVOC
✔️ Langzeitanalyse (Aktivkohlesammler)

Raumluft-Test: Identifizierung & Belastungsindikation.
✔️
Schimmelpilzanalyse
✔️ Sedimentations-Untersuchung
✔️
Ergebnis aus dem Fachlabor

Moderne, pumpenbasierte Innenraumluft-Analyse: Formaldehyd Test
✔️
Formaldehyd Test
✔️
aussagekräftiges, verständliches Ergebnis
✔️ inkl. weiterführender Informationen
